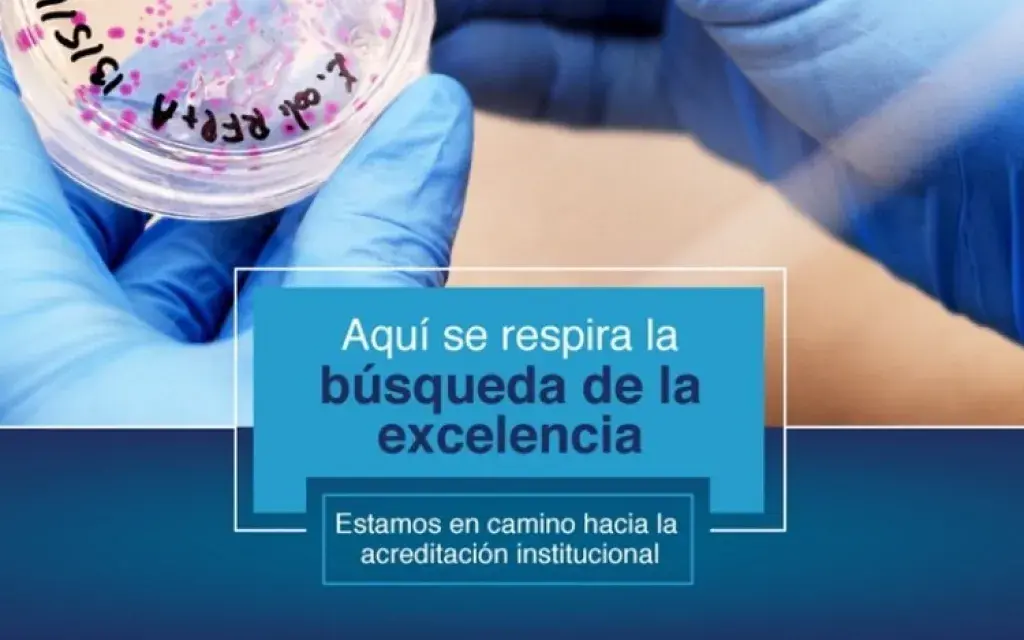

Siguiendo con el compromiso de mejora continua, el Tecnológico de Costa Rica (TEC) apuesta esta vez a la Acreditación Institucional.
Desde el año 1999, el TEC ha venido consolidando el proceso de acreditación de su oferta académica, bajo el lema de la mejora continua. A la fecha estos procesos de acreditación y reacreditación han sido realizados por varias agencias, de acuerdo a la decisión de cada Escuela.
El Sistema Nacional de Acreditación de la Educación Superior (Sinaes) , el Consejo de Acreditación de Ingenieros de Canadá (CEAB), por sus siglas en inglés, la Agencia Centroamericana de Acreditación de Programas de Arquitectura e Ingeniería (Accai) y la Agencia Centroamericana de Acreditación de Postgrados (ACAP) destacan entre las agencias participantes.
Por ese motivo, del 22 al 24 de mayo, un panel de seis expertos del Alto Consejo de Evaluación de la Investigación y la Educación Superior (HCERES por sus siglas en francés) visitará el TEC para evaluar la Institución según sus parámetros y los Criterios y Guías para la Evaluación de Instituciones de Educación Superior del Área Universitaria Europea.
Cabe destacar, que el Consejo Superior Universitario de Centro América (Csuca) firmó un convenio con HCERES con el objetivo principal de incursionar en procesos de acreditación institucional. Con el mismo objetivo, el Sinaes y el Consejo Nacional de Rectores (Conare) firmaron un convenio con HCERES con el fin de desarrollar la evaluación institucional.
También, TEC y HCERES en el mes de enero firmaron un acuerdo, en el cual se establecieron los principales compromisos y plazos asociados con el proceso de evaluación institucional y la posible acreditación.
Esfuerzos conjuntos
En noviembre del 2015, el Rector del TEC, Dr. Julio César Calvo, como presidente del Conare junto con la ministra de Educación, Dra. Sonia Marta Mora, y el presidente de la Conferencia de Presidentes de Universidad Francia (CPU), Jean-Loup Salzmann, y François Cansell, presidente de la Conferencia de Directores de las Escuelas Francesas de Ingenieros (Cdefi) firmaron el convenio de reconocimiento mutuo de diplomas y de períodos de estudios en educación superior, entre universidades costarricenses y francesas.
Luego de esta firma el Dr. Calvo visitó la HCERES con sede en París para evaluar la posibilidad de que el TEC se acreditara institucionalmente con esta agencia, a fin de hacer una autoevaluación con los esquemas europeos y así lograr una acreditación internacional.
Esta iniciativa se convirtió en un proyecto institucional que ha permitido el desarrollo de la autoevaluación, la elaboración del informe de autoevaluación y para la próxima semana la visita de los evaluadores expertos. El TEC es la primera institución en la región en entrar en un proceso de evaluación con miras a la acreditación institucional internacional.
Para iniciar el proceso, el 9 de noviembre se recibió la visita de dos representantes de HCERES, Solange Pisarz y Francois Pernot, quienes expusieron el modelo de acreditación y realizaron la fase de visita exploratoria en el Campus Central, primer paso para la acreditación.
“Como resultado de la visita se definió la hoja de ruta, de manera que a finales del 2017 se haya completado el proceso, que se compone de tres pasos: autoevaluación, visita de expertos evaluadores y decisión final del Consejo de Acreditación de HCERES”, expresó el ingeniero Luis Paulino Méndez Badilla, vicerrector de Docencia del TEC .
Le invitamos a conocer el proyecto en el siguiente enlace .